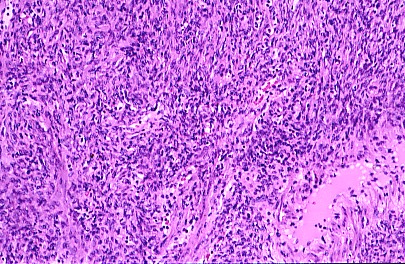
Figura 8

Póster
Nş 077
Póster |
Dr. Agustin Chong Lopez, Dr. Abdulrazzaq Haider, Dr. Gershom C. Ejeckham, Dra. Anita Ramakrishnana *, Dra. Sheikha Al-Thani *, Dra. Nawal Al-Ansari *
|
| La Figura 8 muestra el estroma celular normal conservado en algunas areas subcorticales. H y E x100. |
 |
| La Figura 9 muestra un area central edematosa con un color claro rodeado por estroma celular conservado. H y E x40. |
 |
| La Figura 10 muestra el severo edema intersticial estromal y algunos vasos capilares dilatados. H y E x100. |
 |
| La Figura 11muestra a mayor aumento las caracteristicas celulas estrelladas y fusiformes del estroma edematoso que recuerda un aspecto mixoide. H y E x 400. |